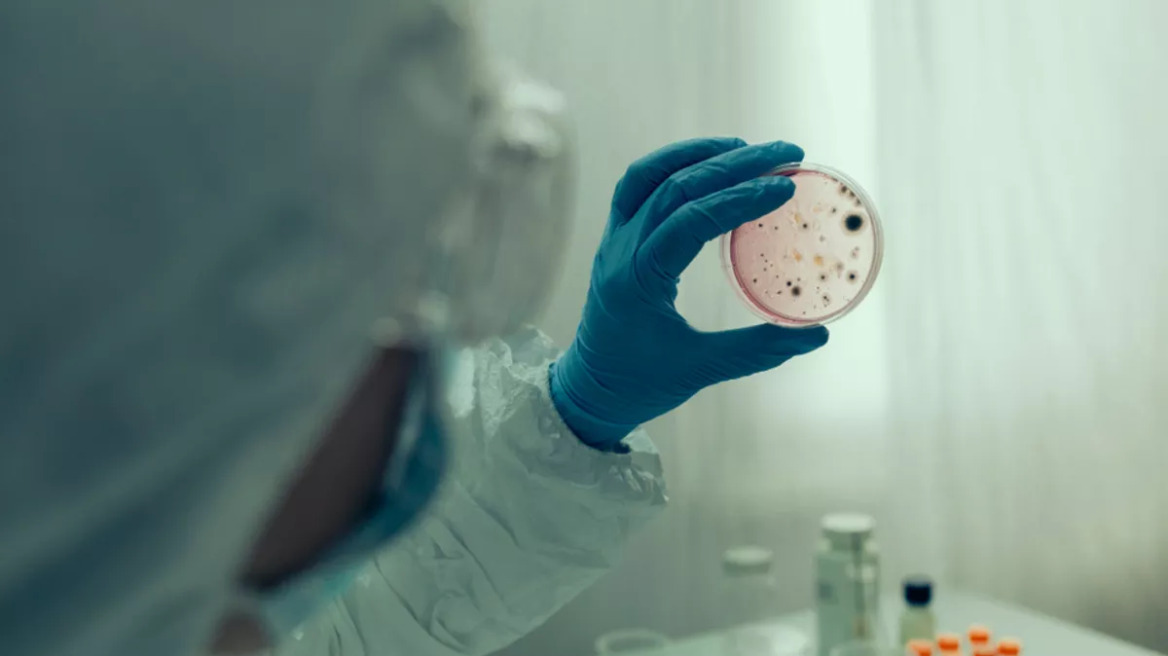
ECDC: Δεύτερο ύποπτο κρούσμα χολέρας στην Πολωνία

ECDC: Δεύτερο ύποπτο κρούσμα χολέρας στην Πολωνία
ECDC: Δεύτερο ύποπτο κρούσμα χολέρας στην Πολωνία
Τα ύποπτα κρούσματα επιβεβαιώθηκαν από το Ευρωπαϊκό Κέντρο Ελέγχου Νοσημάτων - Τι έδειξαν οι εργαστηριακές αναλύσεις για το πρώτο περιστατικό
«Συναγερμός» έχει σημάνει στην Πολωνία για δεύτερο ύποπτο κρούσμα χολέρας, με τις Υγειονομικές Αρχές της χώρας να ενημερώνουν το Ευρωπαϊκό Κέντρο Ελέγχου Νοσημάτων (ECDC).
Στις 21 Ιουλίου 2025, η Εθνική Αρχή Δημόσιας Υγείας της Πολωνίας ανακοίνωσε ύποπτο κρούσμα χολέρας στην Περιφέρεια της Δυτικής Πομερανίας, έπειτα από δημοσιεύματα στον Τύπο που αφορούσαν σε μία ηλικιωμένη γυναίκα, η οποία εμφάνισε γαστρεντερικά συμπτώματα. Η ασθενής νοσηλεύτηκε αρχικά στο νοσοκομείο του Στάργκαρντ και στη συνέχεια μεταφέρθηκε στο περιφερειακό νοσοκομείο του Στσέτσιν, όπου και εξακολουθεί να νοσηλεύται σε σταθερή κατάσταση.
Διαβάστε περισσότερα στο ygeiamou.gr
Στις 21 Ιουλίου 2025, η Εθνική Αρχή Δημόσιας Υγείας της Πολωνίας ανακοίνωσε ύποπτο κρούσμα χολέρας στην Περιφέρεια της Δυτικής Πομερανίας, έπειτα από δημοσιεύματα στον Τύπο που αφορούσαν σε μία ηλικιωμένη γυναίκα, η οποία εμφάνισε γαστρεντερικά συμπτώματα. Η ασθενής νοσηλεύτηκε αρχικά στο νοσοκομείο του Στάργκαρντ και στη συνέχεια μεταφέρθηκε στο περιφερειακό νοσοκομείο του Στσέτσιν, όπου και εξακολουθεί να νοσηλεύται σε σταθερή κατάσταση.
Διαβάστε περισσότερα στο ygeiamou.gr
Ακολουθήστε το protothema.gr στο Google News και μάθετε πρώτοι όλες τις ειδήσεις
Δείτε όλες τις τελευταίες Ειδήσεις από την Ελλάδα και τον Κόσμο, τη στιγμή που συμβαίνουν, στο Protothema.gr
Δείτε όλες τις τελευταίες Ειδήσεις από την Ελλάδα και τον Κόσμο, τη στιγμή που συμβαίνουν, στο Protothema.gr
ΡΟΗ ΕΙΔΗΣΕΩΝ
Ειδήσεις
Δημοφιλή
Σχολιασμένα















































